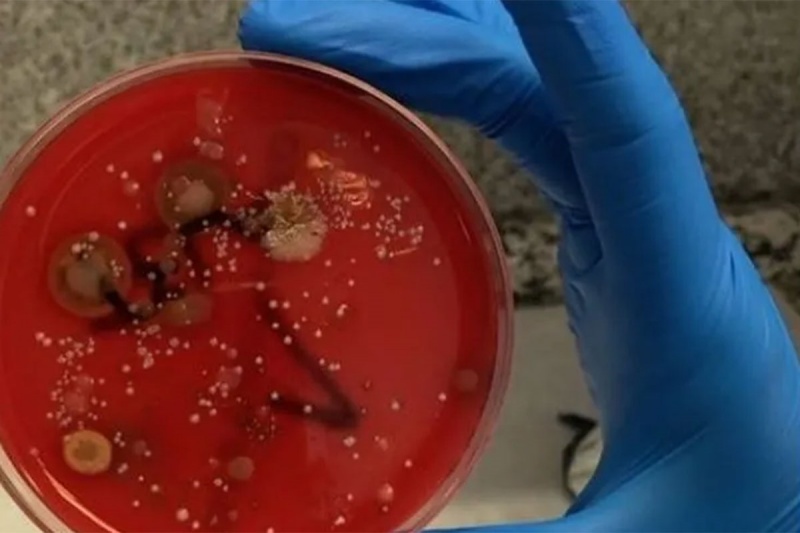

Esto es lo que pasa si no cambias o lavas tu mascarilla
Las mascarillas son la primera barrera protectora contra el coronavirus, pero en ella pueden proliferar las bacterias si no se usan correctamente
- Lancelot Digital
La analista química Marisa García Alonso ha llevado a cabo un experimento, que ha compartido en un didáctico vídeo a través de su cuenta en Instagram, en el que muestra el resultado de no cambiar (o lavar, si es reutilizable) la mascarilla: un cultivo de bacterias entre en el que se pueden encontrar estafilococos, estreptococos, neisserias y bacilos, tal y como publica Diario de Avisos.
Alonso emplea en su experimento una mascarilla que se utilizó durante tres semanas y ocho horas seguidas, siendo esta la más “invadida” de bacterias, aunque evidentemente la cantidad varía según el uso de la mascarilla.
“Esto es una evidencia de algo que ocurre, para que cuidemos mejor nuestras mascarillas, o las cambiemos más a menudo, No es mi intención que alguien concluya no usarlas, y menos cuando podamos correr algún riesgo o que lo corran personas a nuestro alrededor”, aclara en su publicación.
La analista explica además que “las bacterias que aparecen no son patógenas por sí mismas, pero podrían convertirse en patógenas oportunistas si se ven muy aumentadas”.

















